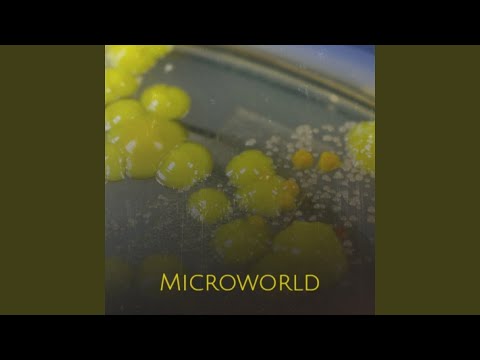

Welcome Back to Original STAFA Band Official Site with New X-Perience!
Welcome Back to Original STAFA Band Official Site with New X-Perience!
Listen to and download MP3 Mr. Walker - Rise Up in high-quality audio for free on Stafa Band. Enjoy streaming online or save the song to your device instantly. Press Play to listen before downloading.